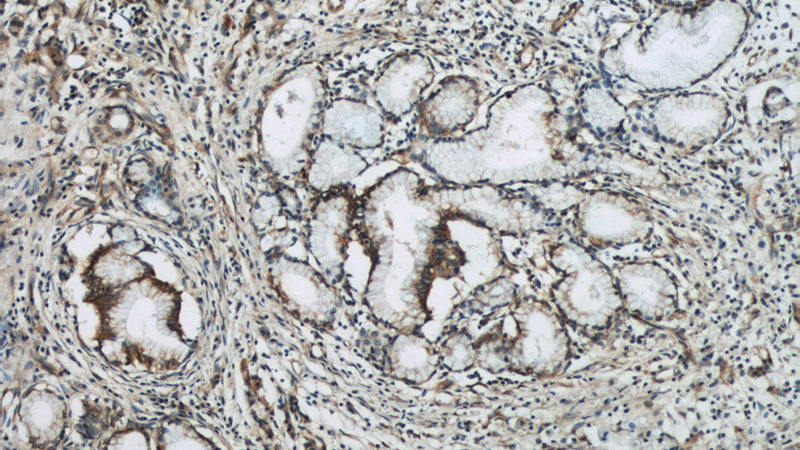
Immunohistochemical of paraffin-embedded human pancreas cancer using Catalog No:115123(SEPT9 antibody) at dilution of 1:50 (under 10x lens)
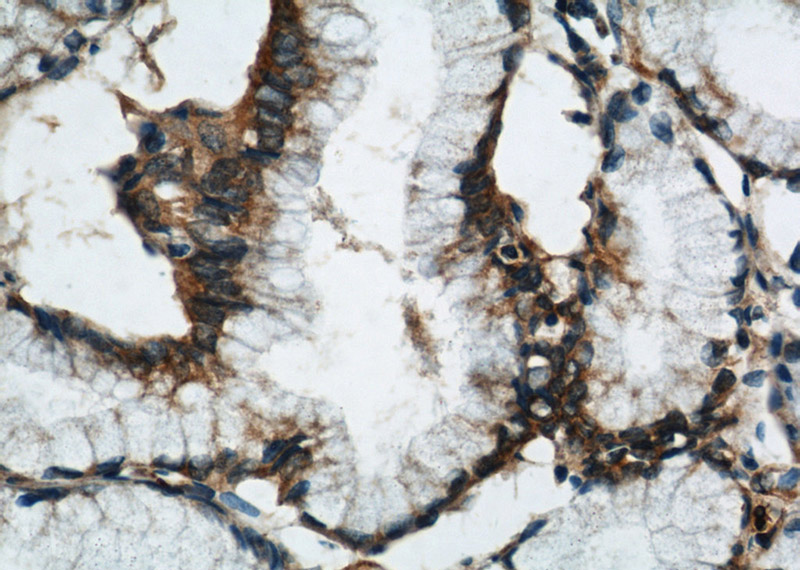
Immunohistochemical of paraffin-embedded human pancreas cancer using Catalog No:115123(SEPT9 antibody) at dilution of 1:50 (under 40x lens)

-
Product Name
SEPT9 antibody
- Documents
-
Description
SEPT9 Rabbit Polyclonal antibody. Positive WB detected in mouse thymus tissue, C6 cells, HeLa cells, mouse brain tissue, mouse spleen tissue. Positive IP detected in mouse brain tissue. Positive FC detected in HepG2 cells. Positive IHC detected in human pancreas cancer tissue, human testis tissue. Positive IF detected in HepG2 cells, Hela cells, hTERT-RPE cells. Observed molecular weight by Western-blot: 65kd,38-40kd
-
Tested applications
ELISA, WB, IHC, IF, FC, IP
-
Species reactivity
Human,Mouse,Rat; other species not tested.
-
Alternative names
AF17q25 antibody; FLJ75490 antibody; KIAA0991 antibody; MLL septin like recombinant protein antibody; MSF antibody; MSF1 antibody; NAPB antibody; Ov/Br septin antibody; Ovarian/Breast septin antibody; PNUTL4 antibody; SEPT9 antibody; SeptD1 antibody; septin 9 antibody; Septin D1 antibody; SINT1 antibody
-
Isotype
Rabbit IgG
-
Preparation
This antibody was obtained by immunization of SEPT9 recombinant protein (Accession Number: NM_006640). Purification method: Antigen affinity purified.
-
Clonality
Polyclonal
-
Formulation
PBS with 0.1% sodium azide and 50% glycerol pH 7.3.
-
Storage instructions
Store at -20℃. DO NOT ALIQUOT
-
Applications
Recommended Dilution:
WB: 1:200-1:2000
IP: 1:500-1:5000
IHC: 1:20-1:200
IF: 1:20-1:200
-
Validations

IF result of anti-SEPT9 (Catalog No:115123, 1:200) with hTERT-RPE cell by Moshe Kim (laboratory of Dr. William S Trimble, University of Toronto). Green: SEPT9. Blue: DNA. Fixation in methanol.

Immunofluorescent analysis of HepG2 cells, using SEPT9 antibody Catalog No:115123 at 1:50 dilution and Rhodamine-labeled goat anti-rabbit IgG (red). Blue pseudocolor = DAPI (fluorescent DNA dye).
Immunohistochemical of paraffin-embedded human pancreas cancer using Catalog No:115123(SEPT9 antibody) at dilution of 1:50 (under 10x lens)
Immunohistochemical of paraffin-embedded human pancreas cancer using Catalog No:115123(SEPT9 antibody) at dilution of 1:50 (under 40x lens)

mouse thymus tissue were subjected to SDS PAGE followed by western blot with Catalog No:115123(SEPT9 antibody) at dilution of 1:600

IP Result of anti-SEPT9 (IP:Catalog No:115123, 4ug; Detection:Catalog No:115123 1:1000) with mouse brain tissue lysate 4000ug.

1X10^6 HepG2 cells were stained with 0.2ug SEPT9 antibody (Catalog No:115123, red) and control antibody (blue). Fixed with 90% MeOH blocked with 3% BSA (30 min). Alexa Fluor 488-congugated AffiniPure Goat Anti-Rabbit IgG(H+L) with dilution 1:1000.
-
Background
SEPT9 represents septin 9
-
References
- Patzig J, Jahn O, Tenzer S. Quantitative and integrative proteome analysis of peripheral nerve myelin identifies novel myelin proteins and candidate neuropathy loci. The Journal of neuroscience : the official journal of the Society for Neuroscience. 31(45):16369-86. 2011.
- Sellin ME, Sandblad L, Stenmark S, Gullberg M. Deciphering the rules governing assembly order of mammalian septin complexes. Molecular biology of the cell. 22(17):3152-64. 2011.
- Menon MB, Sawada A, Chaturvedi A. Genetic deletion of SEPT7 reveals a cell type-specific role of septins in microtubule destabilization for the completion of cytokinesis. PLoS genetics. 10(8):e1004558. 2014.
Related Products / Services
Please note: All products are "FOR RESEARCH USE ONLY AND ARE NOT INTENDED FOR DIAGNOSTIC OR THERAPEUTIC USE"
